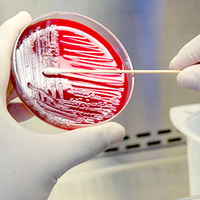

SERVICIOS
Hematología y coagulación
Drogas terapéuticas y de abuso
Parasitología
Genética
Bioquímica
Control de medicamentos
Marcadores tumorales
Inmunología
Microbiología
Alergias e intolerancias
Anatomía patológica
Endocrinología
Extracción a domicilio | Extracción pediátrica |

.jpg/picture-200?_=171f5360390)
.jpg/picture-200?_=171f54ae738)